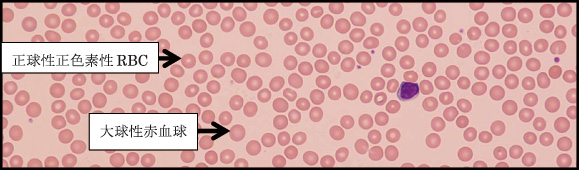

| 東区・郡元支部 (デイジークリニック) 武元 良整 |
|---|
1月号でご紹介しました「かくれ貧血」はメディアで取り上げられた影響で一般に認知されてきている様子です。一方で「ビタミンB12欠乏」症例の患者さんがよく来院されます。その基礎疾患として最も多いのは,重度鉄欠乏性貧血。2番目に多いのが,たちくらみなどの貧血様症状あるも貧血は認めず(Hb:血色素は正常,低フェリチンなし),「倦怠感・たちくらみ,頭痛,動悸,顔面蒼白など」を訴える「かくれ貧血」です。検査結果で初めて「ビタミンB12欠乏」が判明します。この2番目に多い貧血のない「ビタミンB12欠乏」を診断するポイントについて紹介いたします。
症 例:37歳,女性
主 訴:感冒後の倦怠感,たちくらみ,頭痛,胃部不快。
背 景:生理痛でピル内服継続1年。
病 歴:数日来の感冒症状あり,軽快中,上記主訴にて来院。
末梢血検査:CBC(complete blood count)では貧血なし。
| 検査結果 |
| RBC:398万/μL,Hb:12.7g/dL,MCV (mean corpuscular volume:平均赤血球容積):94.2f L,MCH(mean corpuscular hemoglobin:平均赤血球血色素値):31.9pg,PLT(血小板数):13.4万/μL |
臨床経過:血清フェリチン値は正常(126.0ng/mL),血清ビタミンB12値は97pg/mL(基準値180-914)と著減,葉酸値も,3.3ng/mL(基準値4以上)と低値。したがって,典型的なビタミンB12欠乏です。治療はビタミンB12静注で開始。葉酸も低値のため1カ月間内服としました。約1カ月後に倦怠感や頭痛などの症状は軽快し解消。治療終了から1カ月後のCBCは以下。
| 治療終了から1カ月後の検査結果 |
| RBC:432万/μL,Hb:13.7g/dL,MCV:91.9f L,MCH:31.7pg,PLT:21.0万/μL |
ビタミンB12欠乏の17例:
<検査結果>
過去1年間に貧血を認めず(Hb正常)かつ,ビタミンB12が高度に低下した症例(180pg/mL以下)は17例。その中央値を表1に示します。ビタミンB12が正常かどうかは検査後に判明した症例です。
|
| 図 1 末梢血液像:RBC形態はほぼ正球性正色素性で,大小不同をわずかに認めるのみ。 MCV:94.2と正常値(90.0)からすると軽度の大球性赤血球を認める。 (末梢血液画像は鹿児島市医師会臨床検査センター血液検査室へ依頼し撮影いただきました) |

<臨床症状>

ビタミンB12低下の臨床症状は多様です1)。教科書レベルでは,以下の8項目があります。1.疲労,たちくらみ,2.動悸,呼吸速迫,3.顔面蒼白,4.舌痛,5.出血傾向,6.胃不快と体重減少,7.便秘や下痢,8.頭痛。その他,問診の際にありがちな症状に「朝,起床困難」と「記憶力の低下」があります。
まとめ
典型的なビタミンB12欠乏は,通常のCBCでは,表1のように「正常」です。診断のためには,表2の臨床症状とその背景からビタミンB12欠乏を疑い,検査する必要があります。かくれ貧血での低フェリチンと同様にビタミンB12欠乏を診断する決め手は外来で「たちくらみ・疲労・倦怠感」などの訴えに注目することです。
文 献
1.武元良整:健診で貧血を指摘されて(1)~2年間,自覚症状のなかった鉄欠乏性貧血~,鹿児島県医師会報 平成28年9月号:65-67.2016
2.Larry E. Johnson:ビタミンの欠乏症,依存症,および中毒症,メルクマニュアル 第18版 日本語版.Mark H. Beers 他著/福島雅典 総監修 2006年12月
(http://merckmanual.jp/mmpej/sec01/ch004/ch004a.html)
一口メモ(文献2.から改変)
ビタミンB12欠乏症
食事性ビタミンB12欠乏症は通常,腸管からの不十分な吸収により,慢性下痢や完全菜食者に欠乏症が起こることがある。欠乏症により,巨赤芽球性貧血,脊髄および脳の白質への障害,末梢神経障害が有名。診断は血漿ビタミンB12値の測定。シリングテストは,病因を決定するのに役立つ。悪性貧血の診断に有用な内因子抗体測定は保険適応外のため,抗胃壁細胞抗体が有用。治療は経口または非経口によるビタミンB12投与。葉酸は貧血を軽減することがあるが,神経障害を悪化させるため,ビタミンB12の代わりに使用しない。
ビタミンB12は食事から摂取する:主な食品として,肉類,レバ-,魚,栄養強化シリアル,そして乳製品(特にチ-ズなど)。その他「焼き海苔」と一部の「かいわれ大根」にも豊富。
ビタミンB12の働き:赤血球の成熟を促し,神経機能への影響,欠乏により痛みやしびれ,麻痺をきたす。DNA合成に関与しミエリンの合成および修復を助ける。
ビタミンB12欠乏では:巨赤芽球性貧血,貧血以外では錯乱・感覚異常,運動失調。
(C)Kagoshima City Medical Association 2017